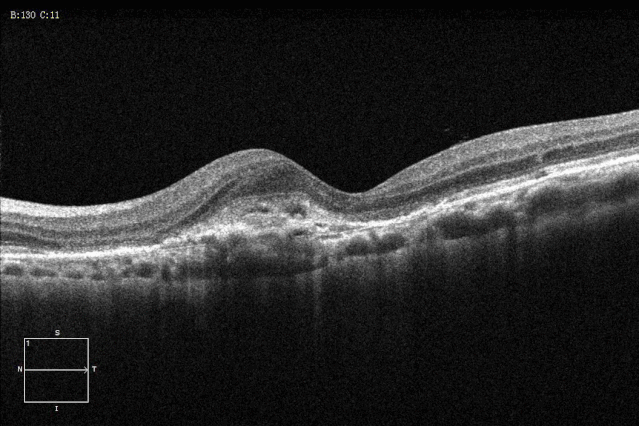
左眼黄斑区亦见黄白色渗出,无明显出血或新生血管

脉络膜新生血管oct

彩图:视盘新生血管,呈团状,不规则,互相有吻合.
图片尺寸2280x1945
ccos眼底疾病丨寻本溯源追根究底文峰教授谈脉络膜新生血管病因学研究
图片尺寸692x693![特发性脉络膜新生血管. [病例帖]](https://imgs.wantubizhi.com/img/A1A61BAA66193547F3A6DD7D8EE527E9C0C34DE249184D489553E51AA2704FF707D1AE03D4B79B95D8828DD301DFD739426CE92E603EEC600FEA95E20EC102A0696FA5453BBEDEE494FF773FEDEB86D369A44BB29AC02B015DB52A1E32D8D234)
特发性脉络膜新生血管. [病例帖]
图片尺寸2736x1824
octa在脉络膜新生血管治疗效果评估中的作用
图片尺寸671x642
弥散型——或称全视网膜——光凝术是治疗增殖性糖尿病视网膜病变的
图片尺寸1200x3308
玻璃体腔重复注射雷珠单抗对脉络膜新生血管患眼脉络膜厚度的影响
图片尺寸700x462
ccos眼底疾病丨寻本溯源追根究底文峰教授谈脉络膜新生血管病因学研究
图片尺寸692x659
结晶样视网膜色素变性合并黄斑区脉络膜新生血管一例
图片尺寸2264x872
左眼黄斑区亦见黄白色渗出,无明显出血或新生血管
图片尺寸639x426
脉络膜新生血管
图片尺寸1080x1439
可伴有视网膜色素上皮萎缩,脉络膜新生血管和视网膜下出血
图片尺寸640x638
1,眼底检查显示黄斑区大片出血(图3左),oct示黄斑区层间出血及rpe层下
图片尺寸425x433
每周最佳病例分享西城杨柳弄春柔新生血管还不休
图片尺寸599x635
脉络膜新生血管期患眼彩色眼底像.
图片尺寸700x602
高度近视脉络膜新生血管光相干断层扫描血管成像特征及黄斑区脉络膜
图片尺寸1594x845
脉络膜新生血管
图片尺寸500x333
糖尿病视网膜眼底(无灌注区,新生血管)
图片尺寸429x334
局灶脉络膜凹陷继发脉络膜新生血管一例
图片尺寸818x570
视网膜下新生血管膜
图片尺寸468x447
一例典型的新生血管性青光眼
图片尺寸3120x4160


![特发性脉络膜新生血管. [病例帖]](https://imgs.wantubizhi.com/img/A1A61BAA66193547F3A6DD7D8EE527E9C0C34DE249184D489553E51AA2704FF707D1AE03D4B79B95D8828DD301DFD739426CE92E603EEC600FEA95E20EC102A0696FA5453BBEDEE494FF773FEDEB86D369A44BB29AC02B015DB52A1E32D8D234)

















![特发性脉络膜新生血管. [病例帖]](https://img1.dxycdn.com/2019/1118/484/3380284908634527372-8w.jpg)